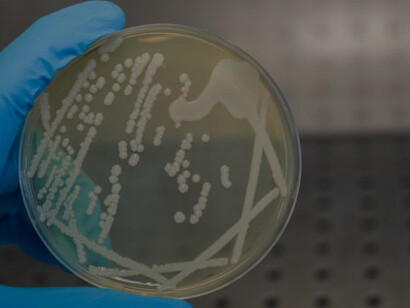
A hand holding a petri dish with isolated bacterial colonies in a bacteriological laboratory's laminar flow cabinet
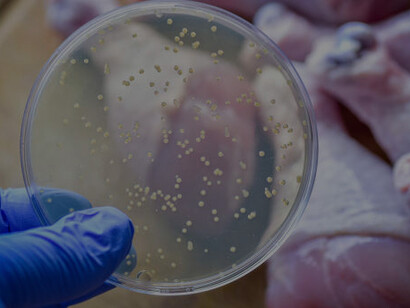
Salmonella and E. coli outbreak linked to chicken meat
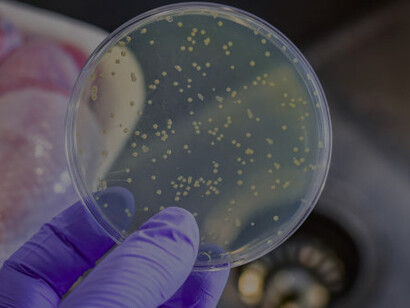
A hand holding a petri dish with Salmonella and E. coli colonies

Ensuring the food we consume is safe and healthy is crucial for maintaining good health and preventing foodborne illnesses. Food microbiology and safety are fields dedicated to understanding and controlling the microorganisms that can affect our food. This article aims to provide a simple and understandable overview of these important topics.
What is food microbiology?
Food microbiology is the study of microorganisms that live in, create, or contaminate food. These microorganisms include bacteria, viruses, yeasts, moulds, and parasites. While some microorganisms are beneficial and essential for food production (like yeast in bread or bacteria in yoghurt), others can cause food spoilage and foodborne illnesses.
Beneficial microorganisms
Beneficial microorganisms play a crucial role in the production of various foods and beverages. For example:
Yeast: used in baking bread and brewing beer, yeast helps dough rise and ferments sugars to produce alcohol.
Lactic acid bacteria: these bacteria are essential for making yoghurt, cheese, and fermented vegetables like sauerkraut and kimchi. They help preserve the food and enhance its flavour and nutritional value.
Molds: certain molds are used in producing cheeses, such as blue cheese and Brie, giving them their unique textures and flavors.
These microorganisms are safe and contribute to the taste, texture, and nutritional value of the food.
Harmful microorganisms
Harmful microorganisms can cause foodborne illnesses, leading to symptoms like stomach cramps, diarrhea, vomiting, and fever. Some common pathogens include:
Bacteria: such as Salmonella, E. coli, and Listeria.
Viruses: such as Norovirus and Hepatitis A.
Parasites: such as Giardia and Toxoplasma.
Food safety basics
Food safety involves handling, preparing, and storing food in ways that prevent foodborne illness. Here are some basic principles:
Clean
Wash hands and surfaces: always wash your hands with soap and water before handling food. Clean surfaces, utensils, and cutting boards with hot, soapy water to remove any potential contaminants.
Rinse fruits and vegetables: rinse produce under running water before eating, cutting, or cooking to remove dirt and any harmful microorganisms.
Separate
Avoid cross-contamination: use separate cutting boards for raw meat, poultry, and seafood. Keep these foods away from other foods, especially those that are ready to eat, to prevent the spread of harmful bacteria.
Store properly: store raw meat, poultry, and seafood in sealed containers on the bottom shelf of the refrigerator to prevent juices from dripping onto other foods.
Cook
Cook to safe temperatures: use a food thermometer to ensure that foods are cooked to a safe internal temperature. For example, cook poultry to an internal temperature of 165°F (74°C), ground meats to 160°F (71°C), and seafood to 145°F (63°C).
Reheat leftovers properly: reheat leftovers to at least 165°F (74°C) to kill any harmful bacteria that may have grown during storage.
Chill
Refrigerate promptly: refrigerate perishable foods within two hours. In hot weather (above 90°F or 32°C), refrigerate within one hour to prevent the growth of harmful bacteria.
Thaw safely: Thaw frozen foods in the refrigerator, cold water, or microwave. Never thaw foods on the countertop, as this can allow bacteria to multiply rapidly.
Common foodborne illnesses
Salmonella: salmonella bacteria are commonly found in raw or undercooked poultry, eggs, and meat. Symptoms include fever, diarrhoea, and abdominal cramps, usually occurring 12–72 hours after infection. To prevent Salmonella infection, cook foods to safe temperatures and avoid consuming raw or undercooked eggs.
E. coli: e. coli bacteria can be found in undercooked ground beef, raw milk, and contaminated produce. Symptoms include severe stomach cramps, diarrhea (often bloody), and vomiting. Cooking meat to safe temperatures and avoiding raw milk can help prevent E. coli infections.
Listeria: listeria bacteria are found in unpasteurized dairy products, deli meats, and smoked seafood. Symptoms include fever, muscle aches, and gastrointestinal issues. Pregnant women, newborns, and individuals with weakened immune systems are particularly vulnerable. Prevent Listeria by consuming pasteurized dairy products and properly reheating deli meats.
The role of the food industry and regulations
The food industry plays a critical role in ensuring food safety. This includes adhering to regulations set by food safety authorities like the Food and Drug Administration (FDA) and the United States Department of Agriculture (USDA) in the United States, or the European Food Safety Authority (EFSA) in Europe. These organizations establish guidelines and standards for food production, processing, and distribution to minimize the risk of contamination.
Advances in food microbiology
Advances in food microbiology have led to improved methods for detecting and controlling pathogens. For instance, rapid detection techniques using molecular biology allow for quicker identification of contaminants, helping to prevent outbreaks. Additionally, new preservation methods, such as high-pressure processing and irradiation, are being used to enhance food safety without compromising nutritional value or taste.
Food safety tips for consumers
Check expiration dates: always check expiration dates on food packaging and consume products before they expire.
Be aware of recalls: stay informed about food recalls and remove any recalled products from your home.
Practice safe shopping: when shopping, pick up perishable items last and ensure they stay cool until you get home.
Understanding food microbiology and safety is crucial for everyone, from food producers to consumers. By following basic food safety practices—cleaning, separating, cooking, and chilling—you can significantly reduce the risk of foodborne illnesses. Staying informed about food safety guidelines and advancements in food microbiology can help ensure that the food you eat is both safe and enjoyable.